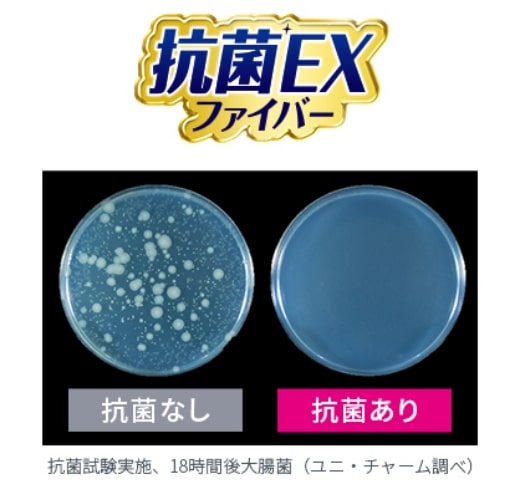

出荷カレンダー
2026年6月
| 日 | 月 | 火 | 水 | 木 | 金 | 土 |
|---|---|---|---|---|---|---|
| 1 | 2 | 3 | 4 | 5 | 6 | |
| 7 | 8 | 9 | 10 | 11 | 12 | 13 |
| 14 | 15 | 16 | 17 | 18 | 19 | 20 |
| 21 | 22 | 23 | 24 | 25 | 26 | 27 |
| 28 | 29 | 30 |
2026年7月
| 日 | 月 | 火 | 水 | 木 | 金 | 土 |
|---|---|---|---|---|---|---|
| 1 | 2 | 3 | 4 | |||
| 5 | 6 | 7 | 8 | 9 | 10 | 11 |
| 12 | 13 | 14 | 15 | 16 | 17 | 18 |
| 19 | 20 | 21 | 22 | 23 | 24 | 25 |
| 26 | 27 | 28 | 29 | 30 | 31 |
■は休業日とさせていただきます。ご注文は年中無休24時間承ります。
■は出荷定休日です。
ご注文は年中無休24時間承ります。
【限定 モネデザイン】 ウェーブ ハンディワイパー ケース付+取り替え2個セット ピンク
【今だけ数量限定】モネデザインのウェーブ ハンディワイパーが登場!
※実際にお届けする商品とパッケージデザインが異なる場合がございます。
- セット内容
- モネデザイン ウェーブ ハンディワイパー 本体+1枚 ピンク
モネデザイン ウェーブ ハンディワイパー 取り替えシート ピンクBOX(白×ピンク 10枚)×2箱


ウェーブハンディワイパーから、
『限定モネデザイン』が発売
簡単キレイなお掃除を提案しているウェーブハンディワイパーから、
柔らかな色使いによって暖かな光を巧みに表現し、
自然の息吹を感じさせる作品で知られる
画家クロード・モネの作品をデザインに採用した
「ウェーブ ハンディワイパーモネデザインシリーズ」を
期間限定品として発売しました。
お部屋に飾って絵画のように楽しめる『限定モネデザイン』を、
ぜひチェックしてみてください♪
モネデザインの魅力
-

お部屋に置いて、絵画のように、
インテリアの一部のように楽しめます。
素敵な絵画デザインで、
いつものお部屋がパッと華やぎます。 -
お部屋に
絵画のように飾る、
見せるお掃除用品
-




お部屋に絵画のように飾る、
見せるお掃除用品
お部屋に置いて、絵画のように、
インテリアの一部のように楽しめます。
素敵な絵画デザインで、
いつものお部屋がパッと華やぎます。
-

ボックスタイプは蓋の開け閉めがしやすい仕様で、取り替えシートの取り出しや詰め替えを簡単に行えます。
また、取り替えシートの収納ケースとして、その後も継続してご使用頂けます。
各ボックスには、取り替えシートが2色入っており、その日の気分に合わせてご使用いただけます。 -
くりかえし使える
取り替え
シートボックス
-




くりかえし使える
取り替えシートボックス
ボックスタイプは蓋の開け閉めがしやすい仕様で、
取り替えシートの取り出しや詰め替えを簡単に行えます。
また、取り替えシートの収納ケースとして、
その後も継続してご使用頂けます。
各ボックスには、取り替えシートが2色入っており、
その日の気分に合わせてご使用いただけます。
ウェーブハンディワイパーの
すぐれた機能
-
無駄なく使えるスマート設計!
とり残していた大きめのホコリ・粒ゴミまでからめとって離さない!
※砂や土などの重いホコリや、量が多すぎると、とり切れないことがあります。
-
抗菌EX*ファイバーでホコリの菌の増殖を抑制
* 抗菌加工部位の表面での菌の増殖のみを抑制。* すべての菌の抑制をするものではない。
-
舞い上げブロックシートがホコリの舞い上げをブロック

※清掃時の空気の流れを確認するため、ドライアイスを使用。
レビュー
おすすめ度
あなたの意見や感想を教えて下さい。
最も参考になったレビュー
1人中、 1人の方が、「このレビューが参考になった」と投票しています。
[ By カッシー ]
普段の生活に必需品のハンディワイパーですが、いままでは使わないときは取り替えシートが入っていた袋に入れていました。いまひとつ見栄えが悪いのと袋からの出し入れが不便でしたが、今回のケースはとても使いやすくデザインもいいのでとても便利です。
このレビューは参考になりましたか?
0人中、 0人の方が、「このレビューが参考になった」と投票しています。
[ By まろん ]
我が家では、犬2匹を家の中で放し飼い?しています。フローリングは、ワイパーなどで完璧ではないにしろ抜け毛はとれます。
ただ、人間の衣服についたわんこの抜け毛が、トイレの床には毎日たくさん落ちるんです。
なんとか出来ないかと考え悩んでいたところへ、ユニチャームさんのおしゃれなモネの絵のカバー付きハンディワイパーのお知らせが。
トイレの換気扇のホコリも取れて快適です。
カバーのおかげで、トイレもおしゃれに。
毎日、気になった時にササッと使って悩み解決です。
このレビューは参考になりましたか?
あなたの意見や感想を教えて下さい。
ご確認ください































